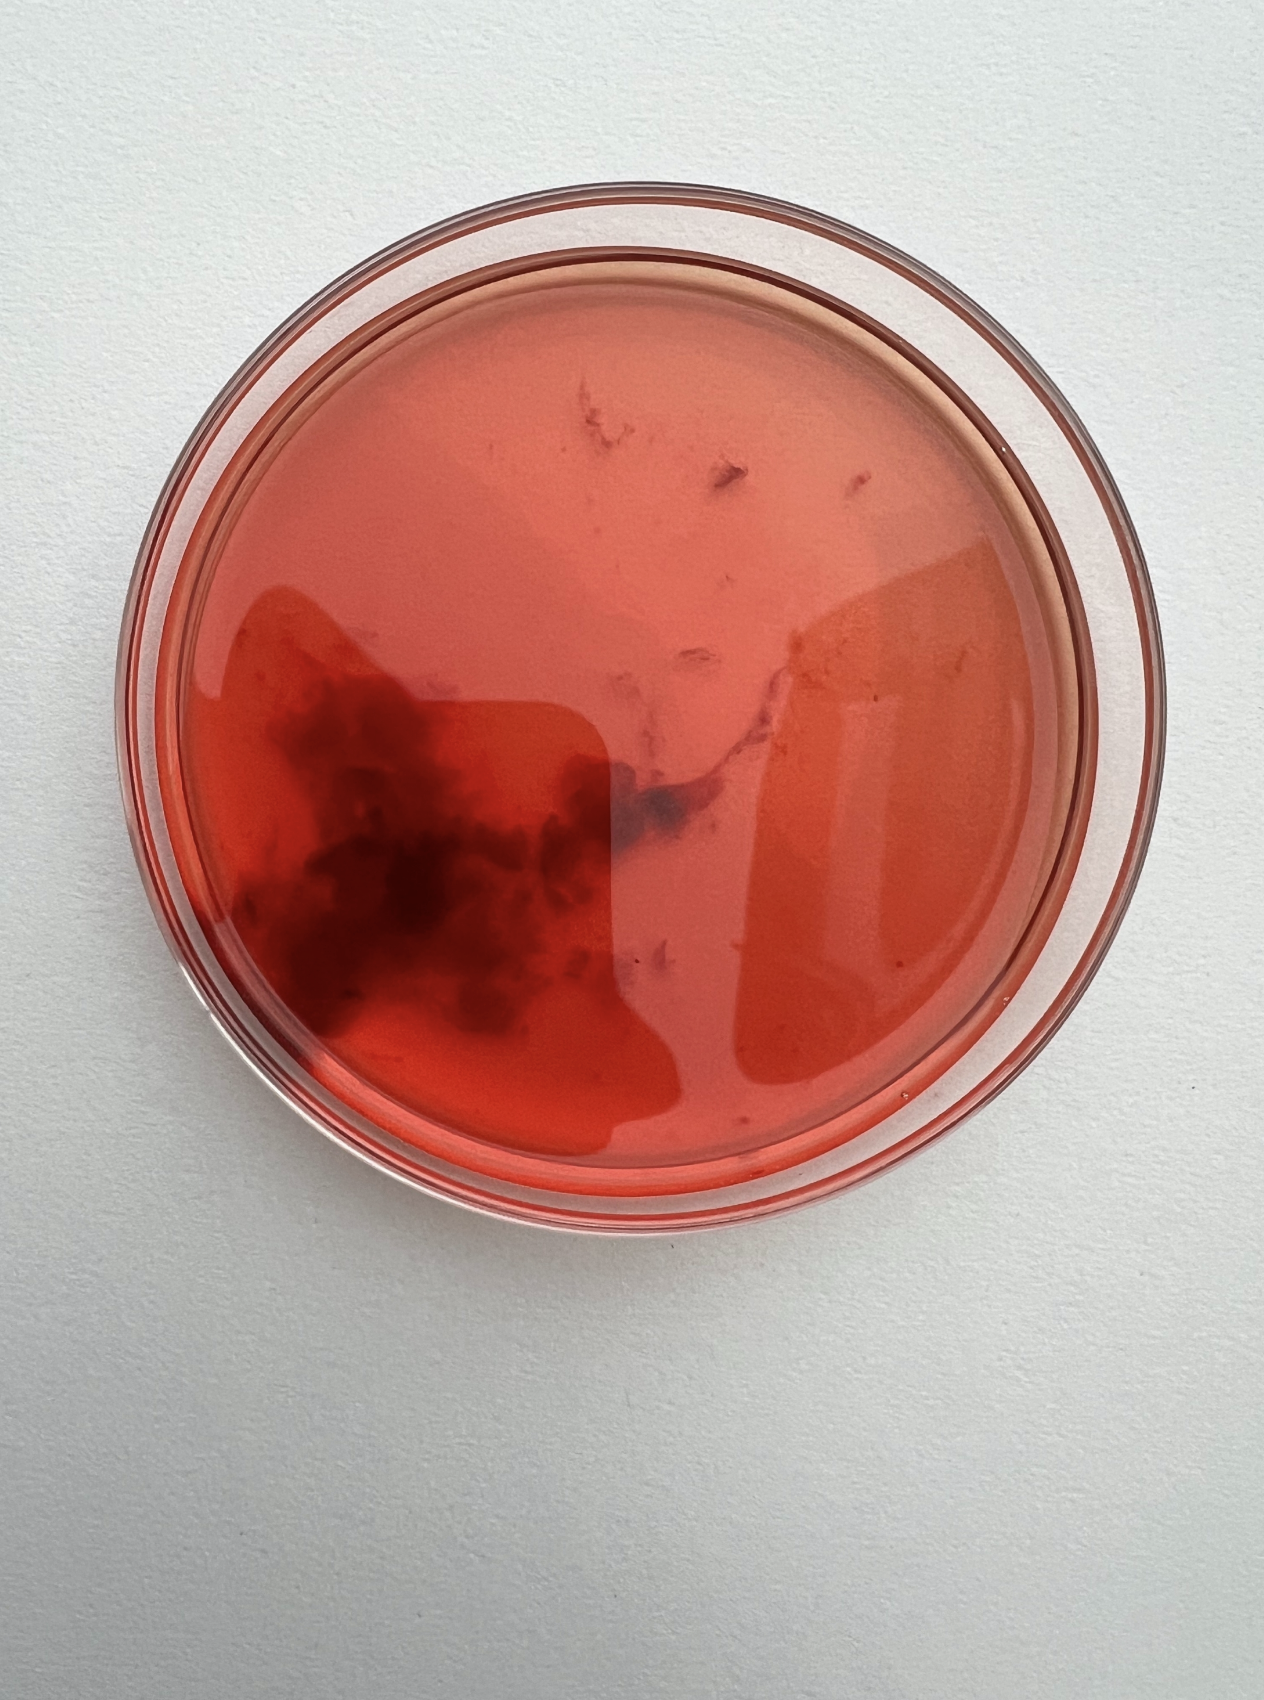
Screenshot 2026-04-13 at 13.01.41.png

Holding both inner & outer realms
Anna’s practice is devotional and ongoing. Working with water, mixed media, and living pattern as portal, she creates rituals, multi-dimensional works, and participatory installations that hold both inner and outer realms. Her work engages alchemical processes and transformational states, exploring the psyche through rhythm, spiral, grief, and deep time, inviting a more conscious relationship with self, place, and the wider ecologies we inhabit.











Holding both inner & outer realms
Anna’s practice is devotional and ongoing. Working with water, mixed media, and living pattern as portal, she creates rituals, multi-dimensional works, and participatory installations that hold both inner and outer realms. Her work engages alchemical processes and transformational states, exploring the psyche through rhythm, spiral, grief, and deep time, inviting a more conscious relationship with self, place, and the wider ecologies we inhabit.
An evolving public installation exploring the sentience of water and the power of collective ancestral repair. Launching in Bruton — August 20-30, 2026.